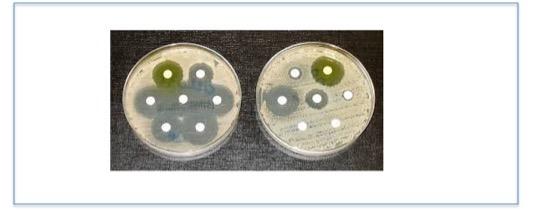

While other public health stories, such as opioid overdose deaths, medical insurance for Americans, new cancer therapies, and Gwynneth Paltrow's vagina dominate health news at this time, bacterial resistance to existing antibiotics quietly marches on. But thanks to PBS, it's not so quiet. The network's PBS NewsHour series “Stopping Superbugs," is not about overblown, silly scares like phthalates in mac and cheese, hexavalent chromium, sunscreen, and glyphosate. It's about bacterial resistance, which is real, deadly, and coming to an organ near you (1).
A segment called "How industrial farming techniques can breed superbugs" features interviews by science correspondent Miles O'Brien with a number of opponents of the use of antibiotics as growth promoters in livestock feed. Two of these are Russ Kremer, a family farmer, farming advocate, and the manager of Heritage Foods, a group of farmers whose goal is to raise hogs “The Right Way…like grandpa used to do,” and Lance Price, Ph.D. a Professor at the George Washington University’s Milken Institute School of Public Health and one of the founders of the Antibiotic Resistance Action Center, which aims "...to bring together epidemiologists, microbiologists, communications experts, policy experts, together under a single roof, working day in and day out, to curb these superbugs and to protect antibiotics." Kremer's and Price's positions regarding this practice could not be more clear.
O'Brien: "[Kremer] was gored in the leg by a boar, and the wound became infected. His doctor told him not to worry, antibiotics were the cure. But it wasn’t that simple."
Kremer: "We tried two different tetracyclines. We tried streptomycin. We tried erythromycin, amoxicillin, seven different antibiotics in total, to no avail...[the antibiotic sensitivity reports] came back, resistant, resistant, resistant, resistant... finally, aha, there was one antibiotic at that time that had some effect on that disease. They treated me, and thank God there were this new-generation drug. And so that transformed my life.
Price: "[O]n every grocery store shelf in this country, I guarantee you you’re going to find drug-resistant bacteria on the meats of those shelves. And then they get in our guts when we consume the meat from those animals."
In another segment "How a flood of antibiotics landed in your chicken" science journalist Maryn McKenna notes that antibiotic resistance is not a "sexy" topic:
“Drug-resistant infections have no celebrity spokespeople, negligible political support and few patients’ organizations advocating for them,” says McKenna, who has written two books on this topic, “Superbug” and “Beating Back The Devil." She argues that, while resistance has largely been blamed on improper prescribing practices by doctors, a worse culprit is the practice of using low doses of prophylactic antibiotics to raise chickens. American Council advisor Dr. David Shlaes, an expert on bacterial resistance, agrees.
In particular, Shlaes objects the prophylactic use of low dose antibiotics in poultry for preventing the spread of infectious disease throughout the brood. Antibiotics are used in this manner to keep the birds healthy and are required because of the way that chickens are raised - in very tight quarters, where infectious diseases can more readily spread. So, prophylactic rather than therapeutic use of antibiotics helps promotes antibiotic resistance when simply improving the conditions under which the birds were raised would help lessen it.
"I still don’t understand why [the FDA] just doesn't ban antibiotics in feed and restrict prophylactic uses to known circulating infections under a veterinarian’s prescription only. And the FDA needs to require that farms and veterinarians track antibiotic use on the farm and report to CDC, similarly to the pilot program the CDC is running in hospitals now."
American Council advisor Dr. David Shlaes
What about the now-controversial practice of finishing all your antibiotics, even if you feel better? This advice has gone unchallenged until recently. Fedor Kossakovski, a production assistant with Miles O'Brien Productions, writes:
"[O]verdosing antibiotics is a bigger threat than underdosing... Yet many health practitioners and patients are so worried about breeding superbugs through underdosing that antibiotics courses are often unnecessarily long."
In other words, the duration of treatment should be tailored to each patient, something that Kossakovski acknowledges will be very difficult for already-overworked doctors. There is not yet a consensus here since under treatment carries its own set of risks, but at least the question is being asked.
In case this isn't scary enough, then try Hunting the Nightmare Bacteria, a 54-minute show which will keep you awake at night way longer than that.
Note:
(1) A new antibiotic was just approved. Vabomere is effective against one of the scariest infections out there - carbapenem-resistant enterobacteriaceae. CRE will kill about half of the people who contract it.